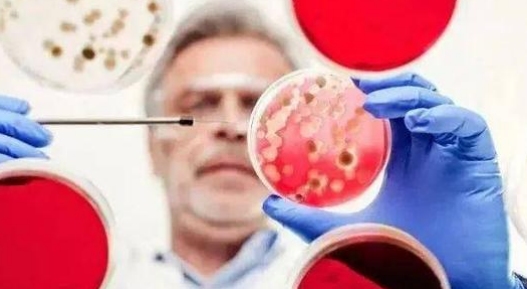
赫赛汀耐药

HER2阳性乳腺癌是人表皮生长因子受体-2(HER2)是重要的乳腺癌预后判断因子。HER系统包括四种表皮生长因子受体,其中HER2对癌细胞的生长和存活有重要作用。“她”和癌细胞结合之后,就会产生“酵素”,酵素一旦被启动,会传递信号,令癌细胞不断分裂繁殖,在患者体内肆虐蔓延。
作为与乳腺癌的转移预后密切相关的基因之一,Er-B-2(HER2)受体的过表达是乳腺癌的发病机制的独立危险因子,成为目前研究的热点之一。HER2蛋白是原癌基因CerbB2(Her2/neu)编码的具有受体酪氨酸激酶(RTK)活性的跨膜糖蛋白,分子量185kDa,简称p185,属表皮生长因子受体酪氨酸激酶家族,能启动酪氨酸激酶调控的信号转导系统。HER2基因与乳腺癌的发生发展及转移有密切关系,HER2过度表达与化疗、内分泌治疗抵抗有关。研究表明,HER2在20﹪~30﹪的原发性乳腺浸润性导管癌中有基因的扩增和蛋白的过度表达,HER2阳性的乳腺癌浸润性强,无病生存期短,预后差。
赫赛汀(Herceptin)是一种针对HER-2/neu原癌基因产物的人源化单克隆抗体,能特异的作用于HER-2受体过度表达的乳腺癌细胞。临床研究已评价了其药代动力学、临床治疗转移性乳腺癌的客观疗效和安全性。1998年获美国FDA批准上市用于治疗HER2阳性转移性乳腺癌。
赫赛汀耐药是什么意思?
赫赛汀的临床应用使部分HER2过表达乳腺癌患者获得临床受益。但单药赫赛汀的客观有效率并不高,为12-34%,且大部分初始接受赫赛汀治疗有效的病人常在1年内产生耐药,加上其费用高昂,所以探讨耐药机制并寻找能够预测赫赛汀疗效的生物学指标对于赫赛汀的临床应用有着重要的意义。
(一) 细胞表面蛋白位阻HER2受体导致赫赛汀无法有效与HER2结合
赫赛汀作为HER2的单克隆抗体,要发挥其作用必须与HER2有效结合。但研究发现,一些细胞表面粘蛋白如MUC4会遮蔽HER2受体,通过位阻阻止赫赛汀与HER2的特异性结合,MUC4高表达与赫赛汀耐药有关。高表达MUC4的小鼠中,赫赛汀与HER2的结合减少。赫赛汀耐药乳腺癌细胞株JIMT-1中MUC4的表达水平较赫赛汀敏感株要高,通过siRNA敲除MUC4表达后,赫赛汀与HER2的结合能力恢复,逆转了赫赛汀耐药。
(二) 可能存在Her2/neu基因突变,影响赫赛汀的疗效
蛋白酪氨酸家族是人类肿瘤中最常发生突变的基因家族。目前报道约10%的肺腺癌患者中发现了编码HER2蛋白酪氨酸激酶区的HER2基因突变,HER2突变型较野生型更具侵袭性和致瘤性,突变型对HER2靶向治疗敏感,但对EGFR酪氨酸激酶抑制剂吉非替尼不敏感[6]。提示ErbB家族基因突变与靶向治疗及预后有关。有趣的是,目前还没有报道发现乳腺癌中HER2基因的突变。
扫描上面二维码在移动端打开阅读